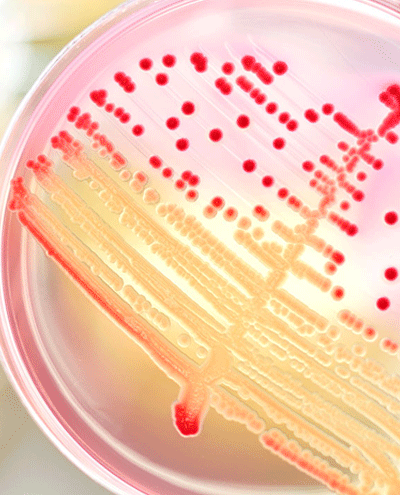

Chemicals by product category
Whether you need equipment and supplies for your laboratory applications, biopharma product support or products ensuring carefully controlled environments at your facility—Avantor can help.
VWR Chemicals are optimised by grade for your application. 98% are available from stock and each has a guaranteed exact specification...
VWR takes care of sourcing, production, testing, and documentation of your chemicals. We manufacture what you need.
Creating your own new molecules? VWR offers extensive ranges of building blocks and equipment to help you...
VWR's range of products and services for production supplies supports customers in manufacturing, assembling and production operations in many industries...
At VWR we think 100% about chromatography, whether its high purity solvents, reagents, columns or consumables...
A large choice of products and services for complete water analysis on-site and in the laboratory...
VWR media products are produced using high quality raw materials and are subject to strict quality controls in a production environment following GMP guidelines...
Key drivers in all industries include the increased capability of instrumental techniques into the ppb, ppt ranges and indeed the requirement for results to be verified and traceable...